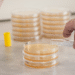
Vai trò của lợi khuẩn L.reuteri Protectis với sức khỏe trẻ sơ sinh image1536785521extractword2out 4108 8729 1758898047.png

Harry Kane đã cán mốc 100 bàn thắng cho Bayern Munich với cú đúp vào lưới Werder Bremen, qua đó viết nên một dấu mốc lịch sử mới ở bóng đá châu Âu.
Harry Kane lập kỷ lục ghi 100 bàn nhanh nhất trong lịch sử
Chỉ cần 104 trận để chạm tới cột mốc 100 bàn, Harry Kane trở thành cầu thủ đạt thành tích này nhanh nhất trong lịch sử các câu lạc bộ thuộc 5 giải vô địch quốc gia hàng đầu châu Âu thế kỷ 21. Trước đó, Erling Haaland và Cristiano Ronaldo đều cần tới 105 trận để ghi 100 bàn cho Manchester City và Real Madrid.
![]() |
| Harry Kane lập kỷ lục ghi 100 bàn nhanh nhất trong lịch sử |
Gia nhập Bayern từ Tottenham vào mùa hè 2023, Kane trở thành cầu thủ thứ 19 trong lịch sử đội bóng xứ Bavaria ghi ít nhất 100 bàn thắng. Chia sẻ với ESPN, tiền đạo người Anh cho biết:
“Tôi đã biết về kỷ lục này, thật khó để không nghe hoặc không nhìn thấy nó. Ghi 100 bàn cho bất kỳ câu lạc bộ nào cũng là thành tựu đáng kinh ngạc, nhưng với một đội bóng như Bayern Munich thì lại càng đặc biệt. Làm được điều đó trong thời gian ngắn nhất, vượt qua cả một trong những huyền thoại như Ronaldo, và người đang trên con đường trở nên vĩ đại như Haaland, là điều khiến tôi vô cùng tự hào. Đây sẽ là kỷ niệm quý giá khi tôi nhìn lại sau này, nhưng hiện tại tôi chỉ muốn tận hưởng nó”.
HLV Vincent Kompany cũng nhanh chóng bác bỏ những đồn đoán về khả năng Kane trở lại Premier League: “Thành thật mà nói, đây không phải chủ đề của chúng tôi. Chúng tôi không bàn về chuyện đó, và cũng không cần thiết. Những gì Kane thể hiện đã nói lên tất cả, và hôm nay lại là một khoảnh khắc tuyệt vời nữa với cậu ấy”.
Ở tuổi 32, Kane vẫn cho thấy phong độ ghi bàn bùng nổ. Tiền đạo người Anh hiện đã có 10 bàn sau 5 vòng đấu ở Bundesliga và 15 bàn trên mọi đấu trường mùa này.
Trong trận gặp Bremen, Kane lập công trên chấm phạt đền ở phút 45 để nâng tỉ số lên 2-0. Đó là quả 11 m thành công thứ 18 liên tiếp của Kane cho Bayern, chuỗi dài nhất lịch sử Bundesliga. Đến phút 65, Kane hoàn tất cột mốc 100 bàn thắng bằng cú dứt điểm lạnh lùng từ đường kiến tạo của Luis Diaz.
Dù còn hướng tới cú hat-trick thứ ba trong mùa giải, Kane được rút ra ở phút 78 trong tràng pháo tay vang dội từ các khán giả tại Allianz Arena. Chung cuộc, Bayern thắng 4-0 khi Konrad Laimer ghi thêm bàn thứ tư cuối trận, qua đó duy trì mạch toàn thắng sau 5 vòng và vững vàng trên đỉnh Bundesliga.
Kane bày tỏ: “Chúng tôi đã xây dựng nhiều thứ từ mùa trước cùng HLV, cách ông ấy muốn chúng tôi chơi và pressing. Tháng này qua tháng khác, toàn đội ngày càng tiến bộ. Mùa giải khởi đầu không hề dễ dàng vì quãng nghỉ ngắn sau Club World Cup, nhưng việc khởi đầu tốt như thế này là nhờ nỗ lực của tất cả mọi người. Còn một chặng đường dài phía trước, nhưng những chiến thắng áp đảo thế này gửi thông điệp mạnh mẽ không chỉ tới phần còn lại của Bundesliga mà cả châu Âu”.
Bayern sẽ tiếp tục chiến dịch Champions League với chuyến làm khách trên sân Pafos vào giữa tuần tới.